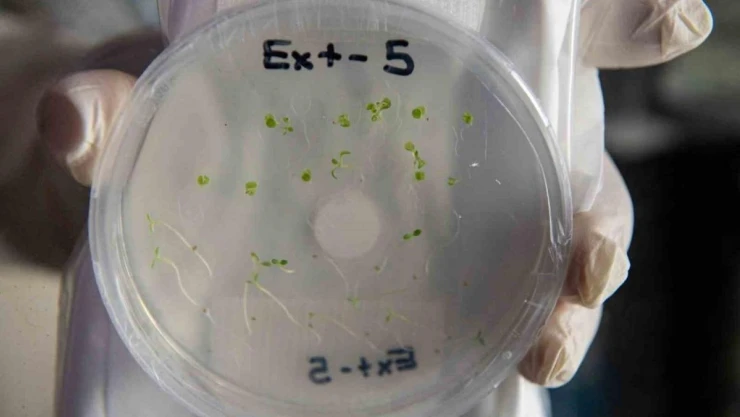

Gezeravcı, uzayda deney yaparken her gün görselleri Egeli ekip ile paylaştı
İlk Türk astronot Alper Gezeravcı, 21 gün süren görevi boyunca çeşitli üniversite ve araştırma kurumları tarafından hazırlanan 13 önemli deney gerçekleştirdi. Gezeravcı, yürütücülüğünü Ege Üniversitesi öğretim üyelerinin yaptığı Tuz Gölünde yetişen Schrenkiella parvula isimli halofit bitkinin uzay ortamına karşı verdiği fizyolojik ve moleküler tepkilerini araştıran ilk deneyinin görsellerini proje ekibi ile paylaştı.
İlk Türk astronot Alper Gezeravcı, 21 gün süren görevi boyunca çeşitli üniversite ve araştırma kurumları tarafından hazırlanan 13 önemli deney gerçekleştirdi. Gezeravcı, yürütücülüğünü Ege Üniversitesi öğretim üyelerinin yaptığı Tuz Gölünde yetişen Schrenkiella parvula isimli halofit bitkinin uzay ortamına karşı verdiği fizyolojik ve moleküler tepkilerini araştıran ilk deneyinin görsellerini proje ekibi ile paylaştı.
İlk Türk astronot Alper Gezeravcı, yurda döndü. Gezeravcı, 21 gün süren görevi boyunca çeşitli üniversite ve araştırma kurumları tarafından hazırlanan 13 önemli deneyi gerçekleştirerek görevini başarıyla tamamladı.
Alper Gezeravcı’nın yaptığı deneylerden biride Ege Üniversitesi öğretim üyelerine ait. Gezeravcı, yürütücülüğünü Ege Üniversitesi Fen Fakültesi Biyoloji Bölümü Doç. Dr. Rengin Özgür Uzilday’ın yaptığı, Doç. Dr. Barış Uzilday ve Prof. Dr. İsmail Türkan’ın araştırmacı olarak görev aldığı "Ekstrem Halofit Olan Schrenkiella Parvula’nın Tuz Stresine Verdiği Yanıtların Uzay Ortamında Araştırılması- EXTREMOPHYTE" isimli projenin deneyini uzayda gerçekleştirdi. Gezeravcı, Tuz Gölünde yetişen Schrenkiella Parvula isimli halofit bitkinin uzay ortamına karşı verdiği fizyolojik ve moleküler tepkilerini araştıran ilk deneyinin görsellerini günden güne proje ekibi ile paylaştı.
Ege Üniversitesi Rektörü Prof. Dr. Necdet Budak, ülke tarihinde yeni bir sayfanın açıldığını söyledi. Rektör Budak, "Ülkemiz, Cumhurbaşkanımız Recep Tayyip Erdoğan’ın liderliğinde başlatılan Milli Teknoloji Hamlesi ve Türkiye Yüzyılı vizyonu kapsamında, önemli projeleri gerçeğe dönüştürmeye devam ediyor. İlk Türk astronot Alper Gezeravcı, uzay misyonunu tamamlayarak döndü. Türk milletinin gurur kaynağı olan Gezeravcı, insanlı ilk uzay görevine ve Türk Uzay Bilim Misyonuna imza atarak, ülkemiz tarihinde yeni bir sayfa açılmasına öncülük etti. Alper Gezeravcı, 21 gün süren görev boyunca, Türk bilim insanları tarafından hazırlanan 13 bilimsel deney gerçekleştirdi. İlk olarak üniversitemiz akademisyenleri yürütücülüğünde hazırlanan Tuz Gölünde yetişen endemik Schrenkiella Parvula isimli halofit bitkinin uzay ortamına karşı verdiği fizyolojik ve moleküler tepkileri araştıran ‘EXTREMOPHYTE’ deneyini gerçekleştirdi. Ege Üniversitesi olarak ülkemize örnek olan bilim ve teknoloji öncelikli ekosistemimizi daha da güçlendirip, bilim ve teknolojide en ileri seviyeyi yakalamak, ‘Türkiye Yüzyılını Türk bilim yüzyılı yapmak için daha çok çalışacağız” diye konuştu.
“İkinci ve üçüncü günde bitkilerin çimlendiklerini gözlemledik”
Deney sürecini anlatan Ege Üniversitesi Fen Fakültesi Biyoloji Bölümü öğretim üyesi Doç. Dr. Barış Uzilday da, “Deney sürecinde fotoğraflar, gündelik olarak bizlere ulaştı. İkinci ve üçüncü günde bitkilerin çimlendiklerini gözlemledik. Bu, bizim için çok önemliydi. Beklediğimiz büyüme seviyesine ulaştıklarını ancak bitkilerin yaprak ve gövde şekillerinin mikro yer çekimi ile farklılık gösterdiğini gördük. Parvula bitkisi Tuz Gölü etrafında yüksek tuza, ağır metallere, düşük ve yüksek sıcaklığa toleranslı, zorlu şartlara adapte olabilen bir bitki. Mars gibi insanların ileride gitmeyi ve tarım yapmayı amaçladığı yerlerde orayı ıslah edebilmeyi sağlayacak öncü özelliklere sahip” dedi.
“Metabolik süreç tamamen durduruldu”
Bundan sonra yaşanacak süreç hakkında bilgi veren Doç. Dr. Uzilday, “Bitkiler, deney sonunda astronotumuz Alper Gezeravcı tarafından hasat edildi. Bir fiksatif solüsyon ile metabolik süreç tamamen durduruldu. Daha sonra Uluslararası Uzay İstasyonunda -80 °C derin dondurucuya aktarıldı. Aynı sıcaklıkta kapsül içinde dünyaya getirildi. Oradan da ülkemize geldi. Bunu takiben biz burada hem bitkilerin büyüme performansı hem de yeni nesil RNA dizilime yöntemi ile hangi genler aktifleşmiş, mikro yer çekimi altında bitki tuza nasıl yanıt vermiş bunları araştırmaya çalışacağız” diye konuştu.
Bakmadan Geçme